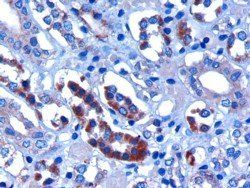
FBXW2 antibody 抗体，orb18575，Bio

相关产品推荐更多 >
万千商家帮你免费找货
0 人在求购买到急需产品
- 详细信息
- 技术资料
- 抗体名:
FBXW2 antibody 抗体
- 抗体英文名:
FBXW2 antibody
- 靶点:
FBXW2
- 浓度:
详询
- 应用范围:
ELISA, IHC, WB
- 宿主:
Goat
- 适应物种:
Bovine, Canine, Human, Mouse, Porcine, Rat
- 保质期:
6-12个月
- 抗原来源:
详询
- 目录编号:
orb18575
- 级别:
科研
- 库存:
99
- 供应商:
Biorbyt
- 标记物:
Unconjugated
- 克隆性:
POLYCLONAL
- 保存条件:
Aliquot and store at -20°C. Minimize freezing and thawing.
- 形态:
详询
- 免疫原:
详询
- 规格:
100 ug
Goat polyclonal antibody to FBXW2
产品名:FBXW2 antibody
货号:orb18575
产品中文名:FBXW2 antibody 抗体
产品详情链接:https://www.biorbyt.com/fbxw2-antibody-orb18575.html


产品主推四大类:
一. 抗体(Antibody):79万种的一抗。可应用于Western blot,IP,IHC,IF,FACS,ELISA等实验。
二. 蛋白(Protien):13万种的高纯度蛋白。
三. elisa试剂盒(Elisa kit):可以提供超过9万种的ELISA试剂盒,包括人源,大鼠源,小鼠源等。
四. 小分子(Small Molecules):超过12万种的生物活性小分子,主要包括:拮抗剂、抑制剂、抗生素、天然产物。
所有Biorbyt品牌的抗体,蛋白,Elisa试剂盒,小分子等产品,国际航空低温运输,货期短,多数产品货期在1~2周,快捷便利。
我们为研究者们提供免费的、专业的、售前售中售后服务,为您的实验保驾护航。
更多详情请联系我们:027-87663101、15827569716。
产品名:FBXW2 antibody
货号:orb18575
产品中文名:FBXW2 antibody 抗体
产品详情链接:https://www.biorbyt.com/fbxw2-antibody-orb18575.html
orb18575 (3ug/ml) staining of paraffin embedded Human Kidney. Microwaved antigen retrieval with citrate buffer pH 6, HRP-staining.

orb18575 staining (0.3ug/ml) of Human Kidney lysate (RIPA buffer, 30ug total protein per lane). Primary incubated for 1 hour. Detected by western blot using chemiluminescence.
产品主推四大类:
一. 抗体(Antibody):79万种的一抗。可应用于Western blot,IP,IHC,IF,FACS,ELISA等实验。
二. 蛋白(Protien):13万种的高纯度蛋白。
三. elisa试剂盒(Elisa kit):可以提供超过9万种的ELISA试剂盒,包括人源,大鼠源,小鼠源等。
四. 小分子(Small Molecules):超过12万种的生物活性小分子,主要包括:拮抗剂、抑制剂、抗生素、天然产物。
所有Biorbyt品牌的抗体,蛋白,Elisa试剂盒,小分子等产品,国际航空低温运输,货期短,多数产品货期在1~2周,快捷便利。
我们为研究者们提供免费的、专业的、售前售中售后服务,为您的实验保驾护航。
更多详情请联系我们:027-87663101、15827569716。
风险提示:丁香通仅作为第三方平台,为商家信息发布提供平台空间。用户咨询产品时请注意保护个人信息及财产安全,合理判断,谨慎选购商品,商家和用户对交易行为负责。对于医疗器械类产品,请先查证核实企业经营资质和医疗器械产品注册证情况。
 技术资料
技术资料暂无技术资料 索取技术资料
FBXW2 antibody 抗体,orb18575,Biorbyt
¥6526










